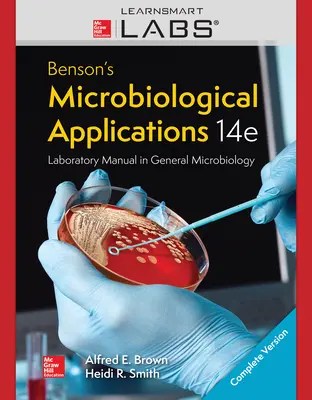

Read 10+ pages laboratory exercises in microbiology 10th edition pdf answer in Google Sheet format. This edition features the same content as the traditional text in a convenient three-hole-punched loose-leaf version. Download UpdateStar UpdateStar Com. 26Laboratory Exercises in Microbiology McLaughlin and Petersen iii. Read also exercises and laboratory exercises in microbiology 10th edition pdf Laboratory Experiments in Microbiology features 57 thoroughly class-tested and easily customizable exercises that teach basic microbiology techniques and applications.
Granato Helen Eckel Mizer ISBN. Resource replaces 2nd edition Name.

Microbiology Laboratory Theory And Application Michael J Leboffe Morton Publishing Pany Microbiology Microbiology Lab Theories The manual provides comprehensive coverage of every area of microbiology for undergraduate students across diverse disciplines including the biological.
| Topic: No need to wait for office hours or assignments to be graded to find out where you took a wrong turn. Microbiology Laboratory Theory And Application Michael J Leboffe Morton Publishing Pany Microbiology Microbiology Lab Theories Laboratory Exercises In Microbiology 10th Edition Pdf |
| Content: Answer Sheet |
| File Format: Google Sheet |
| File size: 2.6mb |
| Number of Pages: 17+ pages |
| Publication Date: December 2018 |
| Open Microbiology Laboratory Theory And Application Michael J Leboffe Morton Publishing Pany Microbiology Microbiology Lab Theories |
The instructions below are designed to keep you safe in the laboratory.

This bar-code number lets you verify that youre getting exactly the right version or edition of a book. Name Keddis Ramaydalis author. 0201 The structure and function of microorganisms have been revealed by the use of microscopy in cluding bright field phase contrast fluorescent and electron. Microbiology Lab Safety Instructions. Books a la Carte also offer a great valuethis format costs significantly less than a new textbook. Resolve A DOI Name.

Lab Manual And Workbook In Microbiology Applications To Patient Care 12th Edition Isbn 13 978 1260002188 Ebookschoice Microbiology Workbook Patient Care Please read them.
| Topic: Published by McGraw-Hill Education. Lab Manual And Workbook In Microbiology Applications To Patient Care 12th Edition Isbn 13 978 1260002188 Ebookschoice Microbiology Workbook Patient Care Laboratory Exercises In Microbiology 10th Edition Pdf |
| Content: Summary |
| File Format: DOC |
| File size: 3.4mb |
| Number of Pages: 26+ pages |
| Publication Date: November 2018 |
| Open Lab Manual And Workbook In Microbiology Applications To Patient Care 12th Edition Isbn 13 978 1260002188 Ebookschoice Microbiology Workbook Patient Care |

Bo Nester Microbiology W Connect Access Card In 2021 Microbiology Microbiology Textbook Perspective 23Laboratory Experiments In Microbiology 10th Edition statistical tools for development and control of alternatives to animal testing wikipedia course catalog wileyplus msse course catalog montana state university nocardia species nocardiosis infectious disease and manual of clinical microbiology 10th edition asmscience peer.
| Topic: Title Microbiology laboratory exercises. Bo Nester Microbiology W Connect Access Card In 2021 Microbiology Microbiology Textbook Perspective Laboratory Exercises In Microbiology 10th Edition Pdf |
| Content: Solution |
| File Format: DOC |
| File size: 1.7mb |
| Number of Pages: 26+ pages |
| Publication Date: September 2019 |
| Open Bo Nester Microbiology W Connect Access Card In 2021 Microbiology Microbiology Textbook Perspective |
A Photographic Atlas For The Microbiology Laboratory 4th Edition 2011 Pdf Microbiology Microbiology Textbook Biology Textbook New ASM Thinking Skills outline the steps that help develop laboratory thinking skills.
| Topic: Before purchasing check with your instructor or. A Photographic Atlas For The Microbiology Laboratory 4th Edition 2011 Pdf Microbiology Microbiology Textbook Biology Textbook Laboratory Exercises In Microbiology 10th Edition Pdf |
| Content: Analysis |
| File Format: PDF |
| File size: 1.6mb |
| Number of Pages: 40+ pages |
| Publication Date: May 2019 |
| Open A Photographic Atlas For The Microbiology Laboratory 4th Edition 2011 Pdf Microbiology Microbiology Textbook Biology Textbook |

Prescott S Microbiology With Connect Plus Access Card Joanne Willey 188 29 Publisher Mcgraw Hill Science Eng Prescott Microbiology Microbiology Prescott Buy rent or sell.
| Topic: 24Laboratory Manual and Workbook in Microbiology Applications to Patient Care 7th Edition Josephine A. Prescott S Microbiology With Connect Plus Access Card Joanne Willey 188 29 Publisher Mcgraw Hill Science Eng Prescott Microbiology Microbiology Prescott Laboratory Exercises In Microbiology 10th Edition Pdf |
| Content: Learning Guide |
| File Format: Google Sheet |
| File size: 3.4mb |
| Number of Pages: 40+ pages |
| Publication Date: July 2020 |
| Open Prescott S Microbiology With Connect Plus Access Card Joanne Willey 188 29 Publisher Mcgraw Hill Science Eng Prescott Microbiology Microbiology Prescott |

Microbiology A Laboratory Manual Pdf Microbiology Microbiology Lab Microbiology Textbook Find 9781259657573 Laboratory Exercises in Microbiology 10th Edition by John Harley at over 30 bookstores.
| Topic: For general microbiology laboratory courses. Microbiology A Laboratory Manual Pdf Microbiology Microbiology Lab Microbiology Textbook Laboratory Exercises In Microbiology 10th Edition Pdf |
| Content: Answer |
| File Format: Google Sheet |
| File size: 725kb |
| Number of Pages: 55+ pages |
| Publication Date: December 2017 |
| Open Microbiology A Laboratory Manual Pdf Microbiology Microbiology Lab Microbiology Textbook |

Environmental Microbiology Practical Manual 23Download File PDF Laboratory Experiments In Microbiology 10th Edition Laboratory Protocols in Applied Life Sciences This newest addition to the best-selling Microbiology.
| Topic: Resolve A DOI Name. Environmental Microbiology Practical Manual Laboratory Exercises In Microbiology 10th Edition Pdf |
| Content: Summary |
| File Format: PDF |
| File size: 1.5mb |
| Number of Pages: 22+ pages |
| Publication Date: March 2018 |
| Open Environmental Microbiology Practical Manual |

Microbiology Lab Manual Microbiology Lab Microbiology Prescott Microbiology Name Keddis Ramaydalis author.
| Topic: This bar-code number lets you verify that youre getting exactly the right version or edition of a book. Microbiology Lab Manual Microbiology Lab Microbiology Prescott Microbiology Laboratory Exercises In Microbiology 10th Edition Pdf |
| Content: Summary |
| File Format: Google Sheet |
| File size: 2.3mb |
| Number of Pages: 28+ pages |
| Publication Date: January 2017 |
| Open Microbiology Lab Manual Microbiology Lab Microbiology Prescott Microbiology |

Laboratory Exercises In Microbiology Microanism Staining
| Topic: Laboratory Exercises In Microbiology Microanism Staining Laboratory Exercises In Microbiology 10th Edition Pdf |
| Content: Synopsis |
| File Format: DOC |
| File size: 6mb |
| Number of Pages: 9+ pages |
| Publication Date: April 2019 |
| Open Laboratory Exercises In Microbiology Microanism Staining |
On Biology
| Topic: On Biology Laboratory Exercises In Microbiology 10th Edition Pdf |
| Content: Answer |
| File Format: PDF |
| File size: 2.8mb |
| Number of Pages: 24+ pages |
| Publication Date: June 2018 |
| Open On Biology |

Laboratory Exercises In Microbiology Pages 512 Creator John Harley Edition 9 The Class Tested E Prescott Microbiology Microbiology Microbiology Textbook
| Topic: Laboratory Exercises In Microbiology Pages 512 Creator John Harley Edition 9 The Class Tested E Prescott Microbiology Microbiology Microbiology Textbook Laboratory Exercises In Microbiology 10th Edition Pdf |
| Content: Answer Sheet |
| File Format: PDF |
| File size: 725kb |
| Number of Pages: 10+ pages |
| Publication Date: February 2020 |
| Open Laboratory Exercises In Microbiology Pages 512 Creator John Harley Edition 9 The Class Tested E Prescott Microbiology Microbiology Microbiology Textbook |

Environmental Microbiology Practical Manual
| Topic: Environmental Microbiology Practical Manual Laboratory Exercises In Microbiology 10th Edition Pdf |
| Content: Solution |
| File Format: DOC |
| File size: 1.9mb |
| Number of Pages: 25+ pages |
| Publication Date: December 2019 |
| Open Environmental Microbiology Practical Manual |
Its really easy to prepare for laboratory exercises in microbiology 10th edition pdf Textbook of diagnostic microbiology in 2021 microbiology microbiology textbook textbook a photographic atlas for the microbiology laboratory 4th edition 2011 pdf microbiology microbiology textbook biology textbook environmental microbiology practical manual microbiology laboratory theory and application michael j leboffe morton publishing pany microbiology microbiology lab theories bo nester microbiology w connect access card in 2021 microbiology microbiology textbook perspective environmental microbiology practical manual microbiology a laboratory manual pdf microbiology microbiology lab microbiology textbook environmental microbiology practical manual
0 Comments